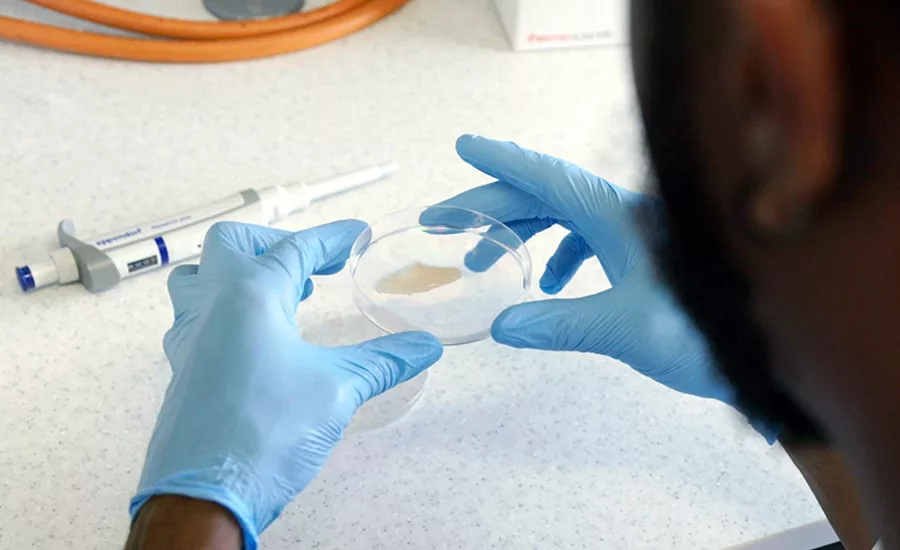
meat safety

Ongoing Improvements to Meat and Poultry Safety
The author examines five current topics in meat and poultry and their implications to protein food
The meat and poultry industries are an interesting mix of conservative practices and innovation. A handful of large players control the bulk of production; yet, numerous small players find their niches. Beef is king. Poultry might be queen, but pork seafood are serious sectors in their own right. The rise of plant-based substitutes and lab-cultured substitutes adds excitement and turmoil. Given this complexity, it is impossible to examine all aspects of new developments in the wider meat and poultry sectors. This article examines five specific topics and their implications to protein food:
- Meat safety as a model for the produce industry
- Increased interest in Salmonella
- Focus on Listeria monocytogenes
- The move toward aggregated sampling
- Developing safety needs for lab-cultivated protein products.
Meat Safety as a Model for the Produce Industry
Periodically, the beef industry is used as an example to the produce industry of how to handle the presence of pathogens. It appears that this comparison is again being promoted. Although it is tempting to accept the acclaim, this comparison may not be ultimately beneficial if it is used to justify testing as the solution to the challenges in produce.
The beef industry's response to the high incidence of hemolytic uremic syndrome (HUS) in 1993 is a case study worthy of review. The details are not rehashed here; but it is important to note that the industry made many changes in response to this event, including more intense testing for Escherichia coli O157:H7. Many attribute the recovery of the beef industry to this increase in testing. This may be a naïve position, as the importance of mitigation steps cannot be overstated. Process improvement is always more effective mitigation than testing.
Despite of these efforts, the beef industry continues to experience recalls. The common N = 60 and N = 60+ testing have a limit of detection (LOD) of about 3 CFU/pound if the sample is assumed to be random (i.e., truly representative). Given that heterogeneity is likely, this standard for sampling is probably not met. If the meat were not largely cooked, this limit of detection would not provide a reasonable level of safety. Instead, it offers the beef industry a reasonable metric for monitoring process performance. E. coli O157:H7 is viewed as an adulterant that contaminates meat during slaughter. U.S. Department of Agriculture (USDA) prescriptive controls promote safe beef to the customer, and USDA cooperates with industry with inspectors in the plants to make this happen.
In contrast, the produce industry and leafy greens processors, in particular, are struggling with outbreaks caused by contamination levels that are lower and, in many cases, much lower than the beef industry's LOD. The produce industry faces the more adversarial regulation by the U.S. Food and Drug Administration (FDA) with a zero tolerance for pathogens. An expert panel estimated that the severe outbreak associated with romaine lettuce in 2018 was caused by contamination at an average of 1 CFU/pound over 50 acres. Additionally, the problem in produce is environmental and not the direct result of processing steps, unless an error occurs.
The levels of pathogen control targeted in the produce industry are not presently practical in meat production. Increased testing can only provide assessment, and will not function successfully as a mitigation. Given the much lower value of the raw commodity and the lower contamination rates, increased testing is not economically feasible. Any comparisons between meat production and produce production with regard to food safety must take into account the many differences in the sectors. This situation is clearly one where each industry should stay in its own lane.
Increased Interest in Salmonella
USDA's Food Safety and Inspection Service (FSIS) recently declared Salmonella to be an adulterant in breaded and stuffed raw chicken products, paving the way for future action in line with FSIS' broader efforts to reduce Salmonella illnesses associated with poultry. However, FSIS also denied a petition filed by Marler Clark LLC asking the agency to declare 31 serotypes of Salmonella as adulterants in meat and poultry products. The pace and scope of future legislative action by USDA to address Salmonella in meat and poultry remains to be seen.
FSIS has a role to promote U.S. agriculture. Regulating these 31 serotypes of Salmonella as adulterants would have many far-reaching consequences. The agency asserts that it "does not believe that there is sufficient data available at this time to support the sweeping actions requested" in the Marler Clark LLC petition. The petition was rejected without prejudice, however, meaning that it can come back with new or improved data.
Looking for quick answers on food safety topics?
Try Ask FSM, our new smart AI search tool.
Ask FSM →
Meat products, particularly poultry, have been implicated in many salmonellosis events each year. At question is whether Salmonella should be considered an adulterant as an "added substance" that "may render injurious" a food contaminated with it, or if the pathogen should continue to be regarded as a "naturally occurring" substance. The contention is that Salmonella is ordinarily injurious in all meat and poultry products regulated by FSIS. Although the agency traditionally has considered Salmonella as naturally occurring in food animals, USDA appears to be reassessing this interpretation and considering whether the pathogen should be deemed an adulterant in any poultry product.
The analytical aspects of Salmonella contamination are daunting. Not all Salmonella are equally virulent. Determining virulence factors will be important to guidance and regulation. Simple presence/absence testing for Salmonella spp. is straightforward with modern molecular methods, but such testing could force the diversion of substantial portions of product to cooked applications. Applying such a testing requirement would burden beef, pork, and poultry differently. Beef positives are lowest, probably due to the extensive efforts to control E. coli O157:H7. Pork testing finds more positives, but still fewer than poultry. These differences make guidance and regulation more complicated. It is difficult to justify setting different levels of tolerance in these three categories of meat if Salmonella were to be declared an adulterant more generally.
USDA is reported to have selected bioMérieux's GENE-UP QUANT as its method of choice for Salmonella enumeration in USDA food safety inspection service labs. This test is reported to deliver quantification results in less than four hours across matrices, removing incubation and growth biases. This raises the question if quantitative tolerances for Salmonella, rather than a presence/absence standard, will be accepted.
Salmonella performance standards have been established to encourage companies to take action to reduce Salmonella in their products. Performance standards hold the industry responsible for maintaining control of pathogens and implementing best practices and intervention technologies to keep their products safe for consumers. Recently, the comment period closed regarding changes to the performance standard for pork products. USDA appears to be committed to continue down this path and continues to collect scientific data and information. The protein food industry can anticipate more opportunities for comment as USDA continues to fine-tune this effort.
USDA seems to have started the process of issuing new regulations for Salmonella in both poultry and pork. New testing requirements are expected in both these industries, stemming from this increased regulation. USDA researchers are actively engaged in validation testing of aggregated sampling techniques that are expected to be included in these regulations. The data collection process for validation is underway at major U.S. meat and poultry producers.
Focus on Listeria monocytogenes
FSIS verification of establishment compliance with Listeria controls is considered to be an important food safety verification activity by FSIS. In March 2022, the directive on Listeria verification activities was updated to provide revised instructions for verifying that meat and poultry establishments are in compliance with the regulatory requirements of 9 CFR 430.4, Control of Listeria in Post-Lethality Exposed Ready-to-Eat Products (the "Listeria Rule"). The revisions reflect changes to clarify that establishments may not release into commerce product that has tested positive for Listeria without reprocessing the product (80 FR 35178). The directive also notes required compliance for products that are not post-lethality exposed (e.g., cook-in-bag), in response to several recent outbreaks implicating products that were incorrectly classified as not post-lethality exposed.
This directive is very prescriptive and provides a safe harbor using Standard Sanitation Operating Procedures (SSOPs) and Hazard Analysis and Critical Control Points (HACCP) for preventing post-lethality contamination of RTE meat products. According to the Listeria Rule, establishments producing post-lethality exposed RTE products must comply with the requirements included in one of the Listeria Control Alternatives to prevent adulteration. Clearly, sanitation is critical to control Listeria in processing facilities. It is reasonable to expect further changes in this area as long as there are outbreaks and recalls. The recent beef jerky event will provide further incentives for FSIS to adjust how facilities control Listeria.
The Move toward Aggregated Sampling
The foundational concepts of aggregated sampling are not new. However, the use of non-woven polyolefin swabs as introduced by lead inventors, Thomas Wheeler and Terrence Arthur of USDA, has led to widespread adoption for the testing of beef trims. Patented sampling swabs utilize this aggregated sampling approach in both a manual method and in a continuous sampling method.
Based on the FSIS letter of no objection and the validation efforts of Wheeler and Arthur, this aggregated sampling approach is displacing the N = 60 and N = 60+ techniques based on tissue excision. The aggregated sampling technique is preferred because no sharp implements are involved, less growth media is required, less hazardous waste is produced, and labor savings are obtained. The IAFP 2022 symposium, "Non-Destructive Superior Sampling," detailed the benefits of this method.1
This trend in sampling is expected to expand into the sampling of poultry and pork, where trials are already underway. The U.S. patent for the sampling swabs presents additional opportunities, including the use of a pocketed sampling device or mitt, which will meet industry needs in these other meat categories. Some validation work still needs to be done, but it is likely that these sampling devices will be included in future guidance on sampling.
Developing Safety Needs for Lab-Cultivated Protein Products
Tissue culture is the latest approach to providing protein food. Recently, plant-based protein food made large gains in consumer acceptance. The technologies behind these improvements will help tissue culture-based competitors gain consumer acceptance with desirable textures and forms. The tissue culture-based category is too new to have a clear understanding of the specific safety challenges. The only certainty is that there will be challenges.
The situation for tissue-culture based products is unique among protein foods. The starting material must be free of contaminating bacteria due to the requirements for incubation and growth of the desired cells. This contrasts with the protein from plants and the protein harvested from animals, which are known to contain some level of pathogens. This difference will likely prompt claims of being "inherently safe." These kinds of claims have been made about controlled environment agriculture (CEA) for produce; however, CEA has already seen its first food safety-related recalls. Tissue-culture protein foods will not be inherently safe.
The position of regulators, at present, is that current guidance for Good Manufacturing Practices (GMPs) and sanitation are sufficient. Hopefully, the practitioners of tissue-culture meat production will adapt to the differences in fabricating food and smoothly transition to these different requirements and any updates or revisions, as necessary. This adaptation may require hiring outside food safety expertise.
Change is good when it is part of a continuous improvement effort. Protein foods have experienced some major changes. When the dust settles, it is hoped that consumers will have some additional safe protein options.
References
- Arthur, Terrance, Daniel DeMarco, and Eric Wilhelmsen. "Non-Destructive Superior Sampling." Presented at the IAFP 2022 Annual Meeting. August 1, 2022, Pittsburgh, Pennsylvania.
Eric Wilhelmsen, Ph.D., C.F.S., is a recognized world authority in food authentication, serving for over 25 years in both academic and industrial positions. In these roles, he has provided technical leadership and innovation for industrial collaborations. His technical contributions and practical innovations have been fundamental in establishing new revenue streams and profitable businesses in juices, dietary supplements and botanicals, agricultural commodities, byproducts, and beverages. He can be reached at the Alliance of Technical Professionals: eric.wilhelmsen@atpconsultants.com.









